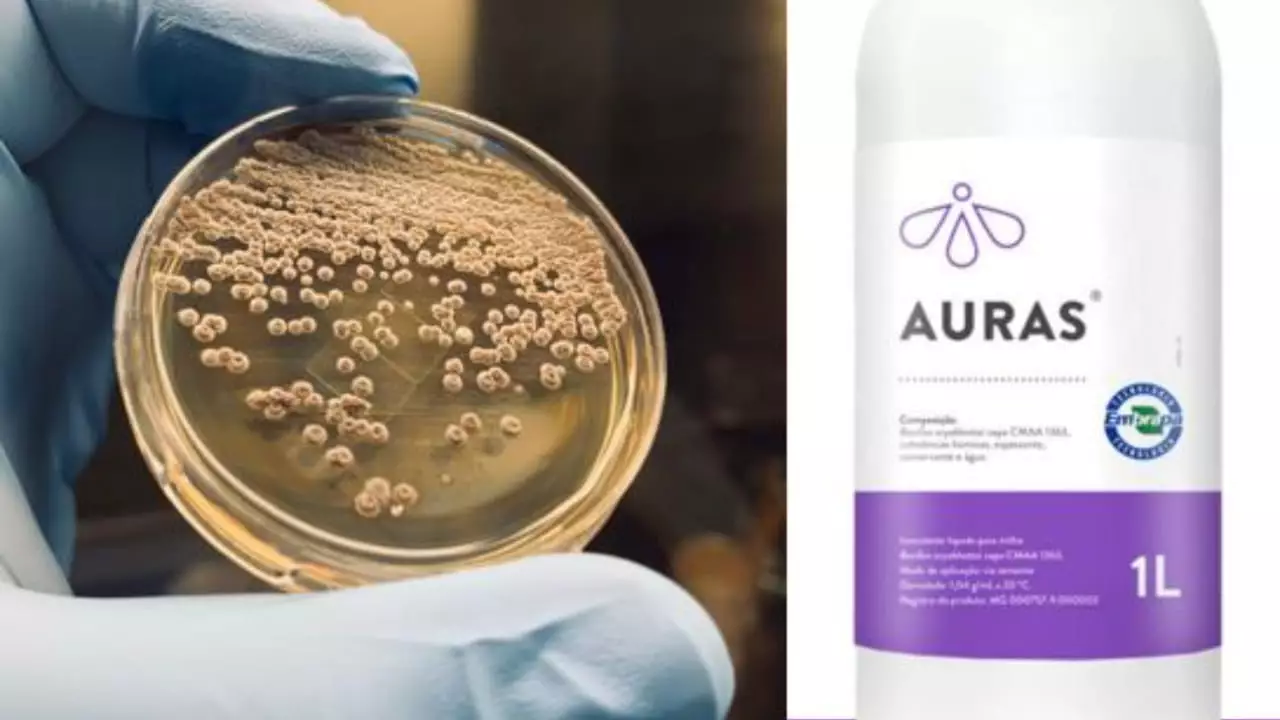
Bioinsumo Auras é feito com a bactéria Bacillus aryabhattai, presente nos solos do Semiárido.

Um bioinsumo desenvolvido pela Embrapa Meio Ambiente em parceria com a empresa NOOA Ciência e Tecnologia Agrícola pode reduzir perdas da soja e outros grãos com a seca, graças à matéria-prima que é o mandacaru da Caatinga.
O bioproduto Auras é resultado de mais de 12 anos de pesquisa e já é usado no milho para combater o estresse hídrico nas plantas, mas também é capaz de reduzir os efeitos causados pelas estiagens prolongadas na soja e trigo, minimizando riscos e em alguns casos potencializando a produção.

Bioinsumo que reduz perdas da soja na seca
A tecnologia é feita à base das raízes do mandacaru (Cereus jamacaru), cacto bem conhecido no Semiárido, que associa microrganismos para tolerar o estresse hídrico. O bioinsumo Auras é feito a partir da bactéria Bacillus aryabhattai, presente nos solos da Caatinga.
Amostras foram coletadas ao longo da Caatinga, em cinco estados: Bahia, Ceará, Piauí, Paraíba e Rio Grande do Norte. Os pesquisadores perceberam que o período de amostragem, chuvoso ou seca, foi o principal fator de alteração na estrutura das comunidades bacterianas, o que permitiu identificar potenciais microrganismos responsáveis pela resiliência ao estresse hídrico.
Para que os microrganismos cheguem às plantas, é feito um procedimento simples na hora de plantar: as bactérias são misturadas às sementes no plantio, em uma suspensão líquida, que pode ser água.
Segundo o pesquisador da Embrapa e líder da pesquisa, Itamar Soares de Melo, os microrganismos são capazes de hidratar as raízes e atuam na fisiologia dos vegetais, fazendo com que respondam melhor à escassez de água.
- Seca x Soja: Veja como reduzir os impactos na safra da cultura
Ação do bioinsumo
Ele explica que as bactérias tolerantes à seca, ao colonizar o sistema radicular das plantas sob estresse abiótico, produzem substâncias que hidratam as raízes, chamadas exopolissacarídeos. O Auras estimula a produção de um sistema radicular mais ativo e profundo, com maior volume de radicelas, proporcionando maior absorção de água.
O aumento de temperatura na planta acima de 30°C traz efeitos negativos na fotossíntese, o que afeta diretamente a produtividade. Com o bioativo, o aproveitamento da água e sua absorção são maximizados, possibilitando à planta melhor controle da temperatura foliar e, consequentemente, uma redução do estresse térmico, em comparação com as lavouras que não utilizam a solução.
Para o diretor técnico da NOOA, Carlos Marcelo Soares, o uso da tecnologia permitiu que as plantas inoculadas sentissem o efeito da estiagem dias mais tarde que as plantas sem a tecnologia, contribuindo para o desenvolvimento dos cultivos em que a solução foi aplicada.
Em entrevista ao Canal Rural, Lucas Carvalho, coordenador de edução de capacitação técnica da NOOA, afirmou que o bioproduto reduz perdas na soja por conta da estiagem de duas a dez sacas, quando aplicado como método preventivo no momento do plantio, dependendo do impacto do ambiente com a genética da planta.
“Esse microrganismo precisa de pouca água para sobreviver, então eles [Embrapa] conseguiram realizar esse isolamento, e estudaram isso nas diversas culturas e hoje nós temos a validação para o produtor usar isso como um fator de proteção na lavoura dele”, conta.







